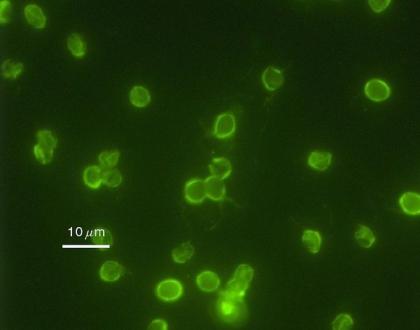

26种恶心的寄生虫
1、跳蚤(Pulex irritans)

世界上大约有2000多种跳蚤。Pulex irritans大多指寄生在人身上的跳蚤,不过它也在某些种类的哺乳动物身上寄生。全世界都能看到跳蚤。
2、人头虱(Pediculus humanus capitis)

这种没有翅膀的昆虫终其一生都在人类的头皮上安家落户。它们产下的卵被称为虱子卵,到处都能找到,尤其是在孩子身上。据估计,美国每年大约有1200万名儿童被它骚扰。
3、体虱(Pediculus humanus humanus)

体虱与人头虱很像,不过这两种寄生虫大约在10万年前就分道扬镖了(那会儿应该刚刚出现衣服)。它在寒冷且拥挤的地方很常见,东战线士兵深受其害。
4、床虱(Cimex lectularius)

床虱靠血生存,它们一生中大部分时候都待在温暖的缝隙中,比如床和沙发。它们晚上会爬到人身上吸血。在有人生活的地方,就会有很多床虱。
5、阴虱(Phthirus pubis)

阴虱通常生活在阴毛中,不过它也能在你的睫毛内生存。只要有人的地方就有阴虱,据估计全球有百分之2-10的人口受到了阴虱的感染。
6、啮齿类动物和鸟类身上的螨(比如鸡皮刺螨)

这种通常在鸟类和啮齿类动物身上生活的螨也会咬人类,包括鸡身上的寄生虫红螨,它在乡下很常见。
7、隐孢子虫
这种原生动物会进入你的肠道,让你忍不住想要大便。它在全世界都很常见。
8、毛囊蠕螨

蛛形纲螨虫,生活在皮肤中,没有肛门。它们死的时候会爆发,将它们的粪便分散到皮肤上。有时候它们会导致酒糟鼻。大约有百分之25的人类皮肤中住着毛囊蠕螨,其中老年人占多数,不过在大部分人身上它不会给人带来任何症状。
9、痢疾内变形虫

一种肠道寄生虫,会在人与人(或其它宿主)之间通过粪便中的包囊相互传染,并造成腹泻。常见于污水处理系统不发达的贫穷国家。
10、恙虫(Trombiculidae)

恙虫不吸血,它们会进入皮肤中分泌出可溶解皮肤的液体,并吸入已溶成液体的皮肤。在北美和欧亚超级大陆中很常见,大约是欧洲西部和亚洲东部这一块。
11、疥螨(Sarcoptes scabiei)

和大部分螨虫不同,疥螨会深入皮肤,造成皮肤发红和刺激感,在任何地方都很常见。
12、罗阿丝虫(Onchocercidae)

一种通过牛虻叮咬传播的蠕虫,它也被称作眼睛蠕虫,因为它能进入眼睛并在眼球表面移动。它在一些非洲国家很常见,全球大约有1200万人受到它的影响。
13、肠贾第虫

单细胞生物,会进入你的肠道中造成腹泻。在俄罗斯圣彼得堡的供水系统中很常见,它在美国也是常见的寄生虫,在发展中国家里没3个人中就有1个人患有这种虫引起的疾病。
14、疥螨类(比如蒲螨)

疥螨类通常依靠昆虫生活,不过如果没有昆虫,它们也会咬其它生物比如人类。全世界都能看到它们的身影。
15、蛲虫(Enterobiasis vermicularis)

蛲虫会在晚上从肛门里出来,并在上面产卵。由于痒,人们会去挠,手指上就会沾上它们的卵,并将其传播到各个地方。它在欧洲西部和美国尤为常见。
16、绦虫(Taenia solium)

它们能长到10米长。它们存在于全世界,但在发展中国家的乡村地区尤为常见,特别是养了猪的地方。
17、旋毛虫

没熟的肉会令你感染上这种虫,它会导致你恶心、呕吐、腹泻和腹痛。它在日本和中国很常见,在欧洲的某些地区相对较为常见。
18、血吸虫(Schistosoma)

生活在淡水蜗牛身上,会导致人类患上血吸虫病。据世界卫生组织统计,2012年有4200万人患有血吸虫病,其中百分之九十来自非洲。
19、鞭虫(Trichuris trichiura)

通过人类拉在土壤中的粪便传播。在发展中国家很常见,在美国南部也时有踪影。
20、大熊猫蛔虫(Ascaris lumbricoides)

另一种通过土壤感染的虫,能在人类肠道中长到35厘米长。它非常常见,全世界大约有20亿人感染了这种虫。
21、钩虫(比如十二指肠钩虫,美洲钩虫和粪类圆线虫)

通常感染它的人身上不会出现什么症状,不过它会引起宿主的肠道问题和贫血。全世界大约有74000万人感染了它,大部分人来自发展中国家。
22、淋巴丝虫(Wuchereria bancrofti)

会侵入你的淋巴系统并导致象皮病(因淋巴系统阻塞而引起的身体肿胀)。这种虫的寿命有7年,它通过蚊虫传播。据世界卫生组织估计,全球大约有12000人感染了它,其中三分之二来自东南亚。
23、弓形虫

它会感染猫和老鼠,并侵入人的大脑。若它侵入老鼠体内,那么老鼠的行为会发生改变,有证据显示它在人体内会做类似的事,让人的反应变慢并神经过敏。美国疾病预防控制中心估计大约有五分之一的美国人受到了它的感染。
24、福氏耐格里阿米巴

食脑寄生虫,人若在被污染的水中游泳就会感染这种虫,大约有百分之95的感染者丧生。它非常罕见,但近几年它在美国很常见。
25、蜱(比如篦子硬蜱)

吸血虫,在全球乡村地区很常见,会造成莱姆病、落矶山斑疹热、埃立克体病和土拉伦斯菌病。
26、人肤蝇(Dermatobia hominis)

蝇的幼虫会在一些哺乳动物身上寄生,包括人类。它大约有2.5厘米长,会在人的皮肤上钻一个洞出来。在美国南部和中部很常见。

发表你的评论吧返回顶部
!评论内容需包含中文
